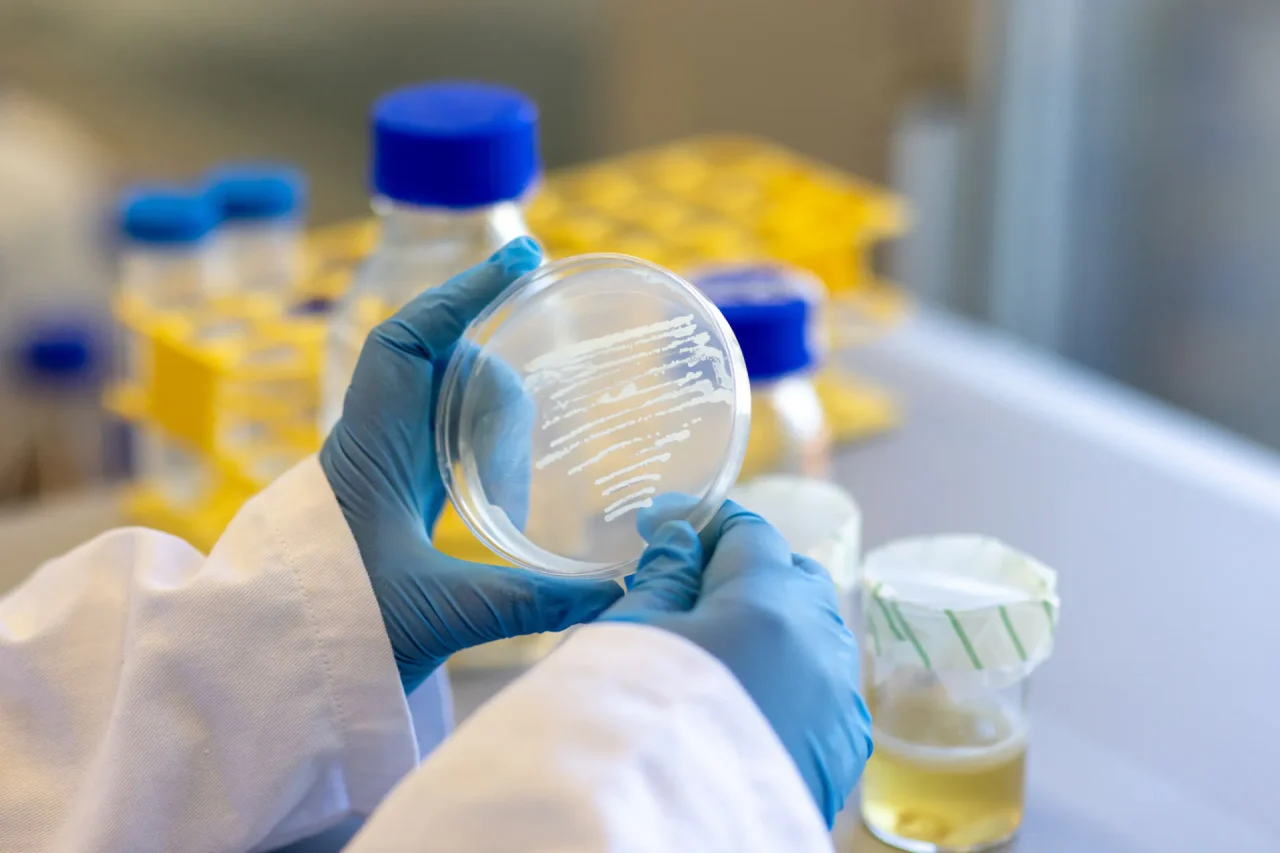

Foamlab raises 3m EUR growth capital to build pilot plant and scale bio-based foams
Delft, The Netherlands – 23 April 2026
Foamlab B.V., a spin-off from Delft University of Technology, has raised a funding round from a consortium of ICOS Capital, Value Factory Ventures, DOEN Ventures, Capricorn Industrial Biotech Fund, and TTT Green Tech Fund managed by SHIFT Invest. The investment enables the company to build a pilot plant, scale production and accelerate the commercial rollout of its bio-based foam materials.
Originating from cutting-edge research from the Faculty of Industrial Design Engineering of Delft University of Technology, Foamlab develops a new class of sustainable foams made from bacterial cellulose, a natural and renewable material grown through fermentation. Each year, millions of tonnes of fossil-based plastic foams are used in packaging, textiles, furniture, and construction- materials that generate persistent waste and are nearly impossible to recycle. Foamlab’s bacterial cellulose-based foams offer a circular alternative by design: bio-based, compostable, and tunable in their properties. From soft, textile-like foams to rigid, structural solutions, Foamlab enables high-performance applications with minimal environmental impact. By collaborating with forward-thinking partners, Foamlab accelerates the transition to a regenerative, bio-based materials economy.
The round is led by ICOS Capital, an investor focused on accelerating the transition to a sustainable and circular economy by backing scalable deeptech solutions with clear market traction. Value Factory Ventures, DOEN Ventures, Capricorn Industrial Biotech Fund, and TTT Green Tech join as co-investors.
Peter van Gelderen, Managing Partner at ICOS Capital:
“We are very pleased to support Foamlab in their next, exciting scale-up phase. Their robust production technology for bacterial nanocellulose foam provides sustainable alternatives for fossil-based materials, for construction insulation, high-end packaging, and fashion, thus addressing a major materials transition with a scalable and sustainable solution.”
Jeroen van Rotterdam, CEO of Foamlab:
“We are very proud to bring together such a strong group of impact investors. We see growing demand for our bacterial nanocellulose foams across multiple industries. This funding enables us to scale production, serve early customers, and accelerate our path to market. Beyond capital, our investors bring hands-on support and valuable networks.”